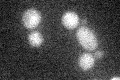
YKR055W
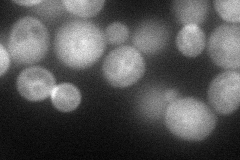
YKR055W
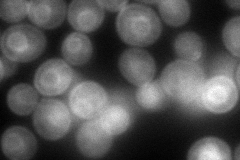
YKR055W
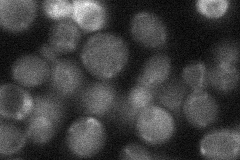
YKR055W
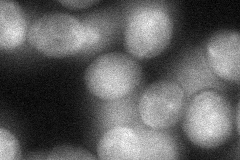
YKR055W
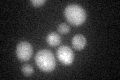
YKR055W

View description
Non-essential small GTPase of the Rho/Rac subfamily of Ras-like proteins, likely to be involved in the establishment of cell polarity
Localization:
Intensity:
Fold change:
Significance:
-
C’ GFP library in SD
below threshold18 -
N' NOP1pr-GFP in SD
cell periphery,ER,bud neck69.1359 -
N' TEF2pr-mCherry in SD
ER,bud neck100.352 -
N' NATIVEpr-GFP in SD
below threshold22.3684 -
N' TEF2pr-VC and Cyto-VN in SD
cytosol44.4134 -
C’ GFP library in SD+DTT
cytosol15.840.87No -
C’ GFP library in SD+H2O2

cytosol16.580.92No -
C’ GFP library in Starvation Media

cytosol22.81.26No -
C’ GFP library on the background of Pup2-DaMP

below threshold -
C’ GFP library on the background of CCT mutant

below threshold16.60110.921424No
